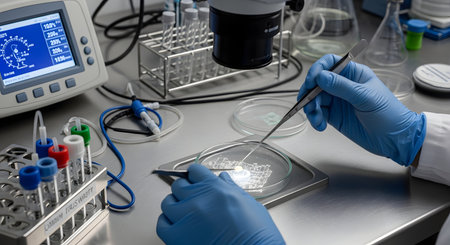
A scientist wearing blue nitrile gloves works meticulously in a modern laboratory, using tweezers to handle a biological sample in a petri dish. The sterile environment includes a microscope, test tubes, and other scientific equipment, representing research and development.の素材

素材 - A scientist wearing blue nitrile gloves works meticulously in a modern laboratory, using tweezers to handle a biological sample in a petri dish. The sterile environment includes a microscope, test tubes, and other scientific equipment, representing research and development.
作品情報
A scientist wearing blue nitrile gloves works meticulously in a modern laboratory, using tweezers to handle a biological sample in a petri dish. The sterile environment includes a microscope, test tubes, and other scientific equipment, representing research and development.
- ID:254383327
- 作品種別:
- 作者名:Mathew Aditya
類似作品
Portrait of a s...
Female doctor b...
scientist worki...
Doctor Explaini...
Close up view o...
Muslim girl in ...
Tired medical w...
Male doctor pou...
Horizontal shot...
Crop close up o...
Doctor in a whi...
Gloved Hand Hol...
Laboratory phar...
The guy in glov...
Mid section of ...
Woman doctor is...
Blue Extractor ...
Man putting on ...
Hand filling sy...
Doctor in medic...
Female lab work...
A dentists hand...
The guy in glov...
Scientist pipet...
Young attractiv...
laboratory assi...
The hand of a d...
Doctor wears bl...
Displaying Empt...
A Hispanic adul...
Close up of fem...
Doctor or Physi...
Doctor medical ...
A blue medical ...
Close Up Doctor...
Woman in blue m...
laboratory assi...
Close u p blue ...
Demonstrating M...
Masked and full...
Researchers wor...
adult man with ...
View of female ...
medic in white ...
A male doctor...
Surgeon's hand ...
Big plastic han...
Peace sign with...
doctor puts on ...